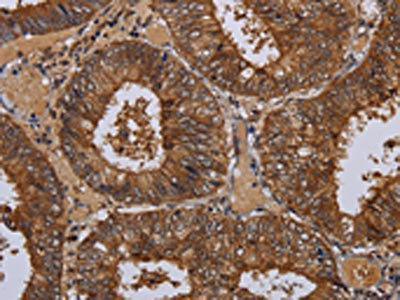

WDR83 Antibody
-
中文名稱:WDR83兔多克隆抗體
-
貨號:CSB-PA552938
-
規格:¥1100
-
圖片:
-
The image on the left is immunohistochemistry of paraffin-embedded Human thyroid cancer tissue using CSB-PA552938(WDR83 Antibody) at dilution 1/60, on the right is treated with fusion protein. (Original magnification: ×200)
-
The image on the left is immunohistochemistry of paraffin-embedded Human colon cancer tissue using CSB-PA552938(WDR83 Antibody) at dilution 1/60, on the right is treated with fusion protein. (Original magnification: ×200)
-
-
其他:
產品詳情
-
Uniprot No.:
-
基因名:WDR83
-
別名:MAPK organizer 1 antibody; MGC4238 antibody; Mitogen activated protein kinase organizer 1 antibody; Mitogen-activated protein kinase organizer 1 antibody; MORG 1 antibody; WD repeat domain-containing protein 83 antibody; wdr83 antibody; WDR83_HUMAN antibody
-
宿主:Rabbit
-
反應種屬:Human,Mouse,Rat
-
免疫原:Fusion protein of Human WDR83
-
免疫原種屬:Homo sapiens (Human)
-
標記方式:Non-conjugated
-
抗體亞型:IgG
-
純化方式:Antigen affinity purification
-
濃度:It differs from different batches. Please contact us to confirm it.
-
保存緩沖液:-20°C, pH7.4 PBS, 0.05% NaN3, 40% Glycerol
-
產品提供形式:Liquid
-
應用范圍:ELISA,IHC
-
推薦稀釋比:
Application Recommended Dilution ELISA 1:2000-1:10000 IHC 1:100-1:300 -
Protocols:
-
儲存條件:Upon receipt, store at -20°C or -80°C. Avoid repeated freeze.
-
貨期:Basically, we can dispatch the products out in 1-3 working days after receiving your orders. Delivery time maybe differs from different purchasing way or location, please kindly consult your local distributors for specific delivery time.
-
用途:For Research Use Only. Not for use in diagnostic or therapeutic procedures.
相關產品
靶點詳情
-
功能:Molecular scaffold protein for various multimeric protein complexes. Acts as a module in the assembly of a multicomponent scaffold for the ERK pathway, linking ERK responses to specific agonists. At low concentrations it enhances ERK activation, whereas high concentrations lead to the inhibition of ERK activation. Also involved in response to hypoxia by acting as a negative regulator of HIF1A/HIF-1-alpha via its interaction with EGLN3/PHD3. May promote degradation of HIF1A. May act by recruiting signaling complexes to a specific upstream activator. May also be involved in pre-mRNA splicing.
-
基因功能參考文獻:
- Morg1 facilitates Par6-aPKC binding to Crb3 for definition of apical identity of epithelial cells. PMID: 23439680
- WDR83 and DHPS were capable of forming an RNA duplex at overlapping 3' untranslated regions and this duplex increased their mutual stability, which was required for the bidirectional regulation. PMID: 22491477
- Includes the identification of this protein in C complex spliceosomes. PMID: 11991638
- Functional characterization of the homologous rat gene. PMID: 16407229
- Component of a modular scaffold system that participates in the regulation of agonist-specific ERK signaling. PMID: 15118098
- Morg1 expression is reduced in human brain tissue with ischemic damage. Reactive astrocytes in the surrounding brain tissue showed strong Morg1 expression. PMID: 19429104
顯示更多
收起更多
-
亞細胞定位:Cytoplasm. Nucleus.
-
蛋白家族:WD repeat MORG1 family
-
數據庫鏈接:
Most popular with customers
-
-
YWHAB Recombinant Monoclonal Antibody
Applications: ELISA, WB, IHC, IF, FC
Species Reactivity: Human, Mouse, Rat
-
-
-
-
-
-